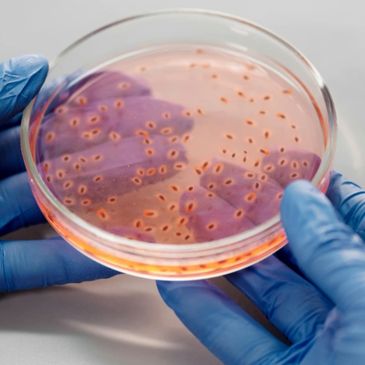

Free shipping on all U.S. orders with no minimum required
Free shipping on all U.S. orders with no minimum required

High-Yield content and 1,000 Board-Style MCQs with Explanations

High-Yield content and 1,000 Board-Style MCQs with Explanations
High-yield timed 1,000 Board-Style MCQs with Explanations on Udemy
Copyright © 2025 Master Series Books - All Rights Reserved.
Trusted & Respected Globally
We use cookies to analyze website traffic and optimize your website experience. By accepting our use of cookies, your data will be aggregated with all other user data.